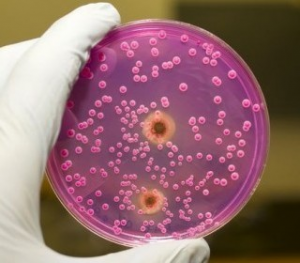
кандидоз кандидоз

Как избавиться от молочницы в домашних условиях?

Этиология и причины заболевания
Урогенитальный кандидоз – заболевание грибковой этиологии, обусловленное ростом и размножением условно-патогенного гриба рода Candida. К повышению его активности могут приводить следующие факторы:
- нарушение постоянной микрофлоры влагалища в результате нерационального применения антибактериальных средств, которые подавляют жизнедеятельность не только патогенной флоры, но и облигатных микроорганизмов, выполняющих защитную роль;
- ослабление иммунной защиты в результате наличия хронических заболеваний, переутомления, стресса, гиповитаминоза, резкой смены климата;
- приём комбинированных оральных контрацептивов, с высоким содержанием эстрогенов;
- наличие сахарного диабета – сопровождается повышенным содержанием сахара в эпителии слизистой половых путей, что способствует росту колонии грибка;
- инфицирование из кишечника – желудочно-кишечный тракт представляет собой резервуар обитания грибов рода Candida;
- начало половой жизни – приводит к изменению микрофлоры, дисбактериозу;
- беременность – на фоне гормональных изменений происходит нарушение кислотно-щелочной среды влагалища, при этом иммунная защита у беременных женщин снижается за счёт иммуносупрессивного влияния прогестерона.
Симптомы заболевания
К признакам появления молочницы у женщин относятся следующие проявления:
- появление густых, белых выделений, напоминающих творог и имеющих кисломолочный запах;
- интенсивный зуд, чувство жжения, которые усиливаются после принятия ванны, физической активности, полового контакта;
- при осмотре отмечается покраснение и отёк слизистой;
- во время полового акта беспокоит боль и неприятные ощущения.
Молочница у лиц мужского пола встречается намного реже и свидетельствует о нарушении иммунитета, возможном наличии скрытых половых инфекций. Признаком патологии у мужчин является:
- появление на головке полового органа творожистого налёта белого цвета;
- признаки кандидозного баланита – покраснение, отёк головки и крайней плоти;
- боль при половых контактах, зуд, жжение.
Как вылечить молочницу в домашних условиях
Чем лечить заболевание дома? Помогут избавиться от молочницы в домашних условиях следующие методы:
- Соблюдение принципов питания – ограничение мучных продуктов, сладостей, увеличение в рационе количества свежих овощей, сезонных фруктов, молочных и кисломолочных продуктов. Для улучшения иммунного статуса организма полезны витаминные морсы из ягод (клюквенный, брусничный), отвар шиповника.
- Применение настоев и отваров следующих лекарственных трав:
- Календула ― обладает противомикробным, ранозаживляющим действием. Для приготовления раствора в термос засыпают две чайных ложки травы, добавляют стакан кипятка, плотно закрывают крышкой и настаивают полчаса.
- Кора дуба ― при местном применении оказывает противовоспалительный, вяжущий эффект, хорошо сочетается с другими травами. В эмалированную посуду помещают 30 грамм измельчённой коры, добавляют стакан воды. Ставят на водяную баню и кипятят в течение 10 минут.
- Зверобой ― уменьшает боль, воспаление и ускоряет процесс регенерации. К 2 чайным ложкам травы добавляют стакан тёплой воды, кипятят на водяной бане 20 минут.
- Чистотел ― оказывает противогрибковое, противозудное, противовоспалительное действие. Столовую ложку чистотела заливают стаканом воды, доводят до кипения, настаивают в течение четырёх часов под плотно закрытой крышкой. Применять следует с осторожностью, так как трава содержит алкалоиды и относится к ядовитым растениям.
- Ромашка ― является природным антисептиком, обладает противовоспалительным, действием.
Отвары и настои трав можно применять следующим образом:
- проведение сидячих ванночек ― утром и вечером в течение не менее чем 15 минут;
- использование марлевых тампонов, смоченных в отварах трав – целесообразно применять на ночь, предварительно пришив к тампону крепкую нитку;
- спринцевание – желательно использовать однократно в сутки, например, перед сном. Более частые процедуры приводят к вымыванию полезных лактобактерий, которые в норме сдерживают рост патогенной флоры. Таким образом, злоупотребление этим методом может привести к ухудшению самочувствия, усилению симптоматики и присоединению бактериального вагиноза.
Местное применение раствора пищевой соды приводит к нейтрализации кислой среды влагалища, способствует устранению симптомов. Для приготовления раствора для спринцеваний разводят чайную ложку порошка в стакане тёплой воды, можно добавить 8-10 капель спиртового раствора йода. Для проведения сидячих ванночек раствор готовят из расчёта столовая ложка соды на литр воды.
Лечение партнёра проводится при наличии признаков кандидозного баланита, а также в случае появления болевых ощущений во время половых контактов.
Профилактика заболевания
Для профилактики развития болезни рекомендуется следовать определённым правилам:
- рационально использовать антибактериальные средства;
- своевременно устранять дефекты иммунной системы;
- использовать нижнее бельё из хлопчатобумажных тканей;
- не злоупотреблять спринцеванием, влагалищными антисептиками;
- соблюдать личную гигиену;
- контролировать содержание углеводов в рационе.
Лечение молочницы народными средствами зачастую быстро устраняет проявления заболевания, однако не способно помочь избавиться от болезни навсегда, так как применяемые средства действуют на поверхности слизистой и не оказывают выраженного фунгицидного воздействия. Для полного излечения требуется применение системных антимикотиков. Поэтому прежде чем начинать бороться с недугом самостоятельно, желательно обратиться к врачу-специалисту.













Добавить комментарий